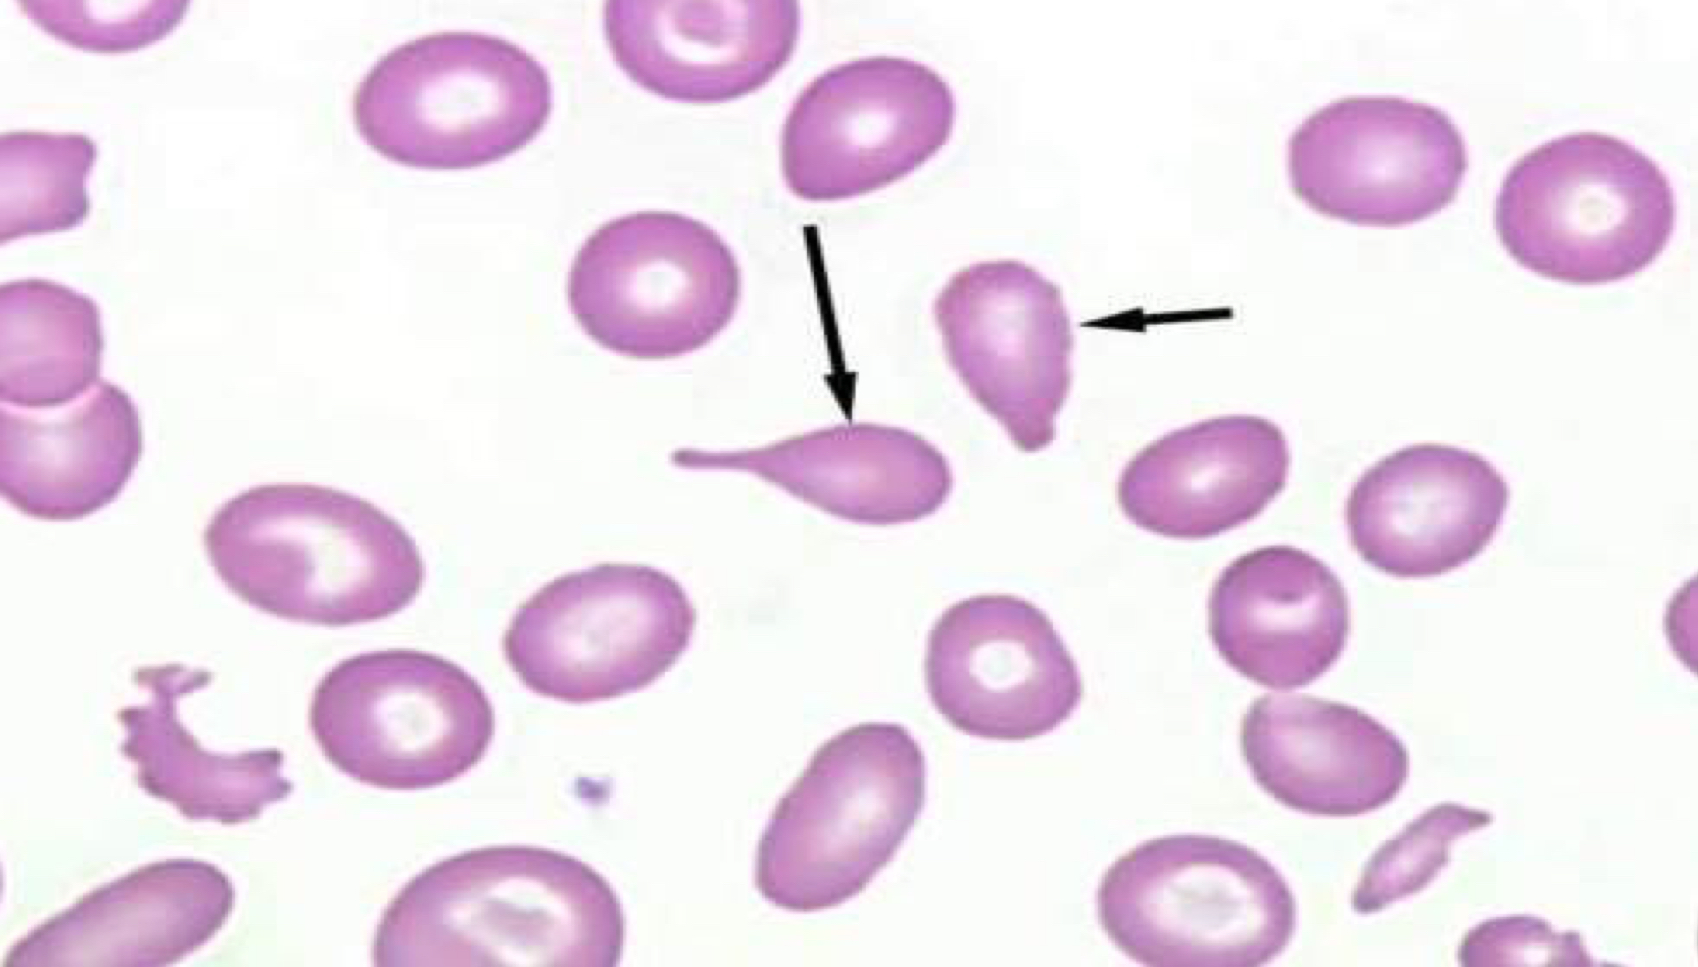
term image
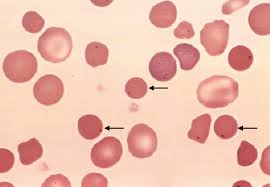
<p></p>
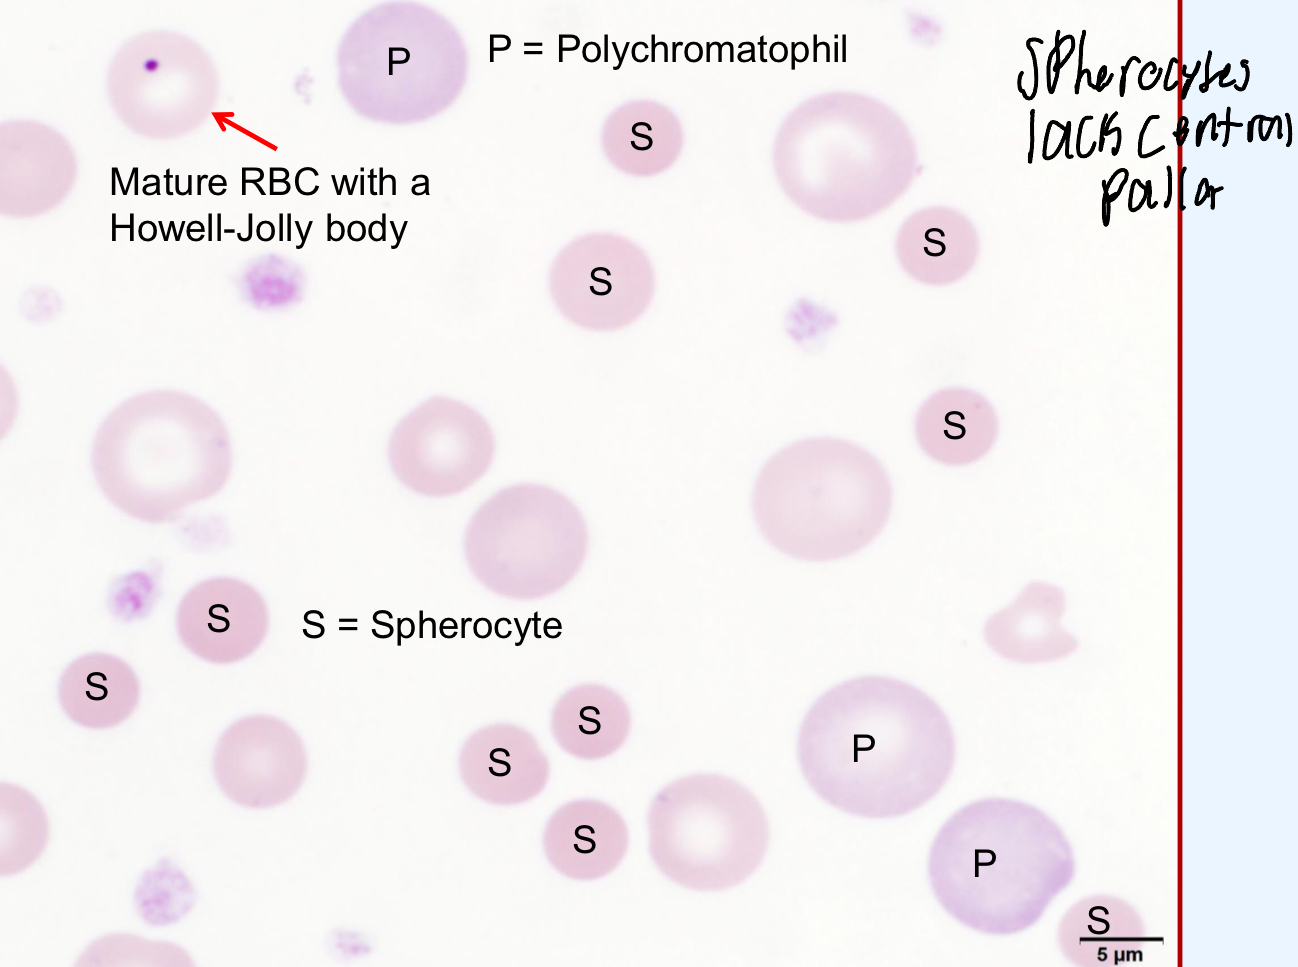
<ul><li><p><strong><u>IMHA (very common)</u></strong></p></li><li><p>Fragmentation hemolysis</p></li><li><p>Envenomation</p></li><li><p>Zinc toxicosis</p></li></ul><p></p><p>IMHA is at the top of your differential list when spherocytes are present</p>
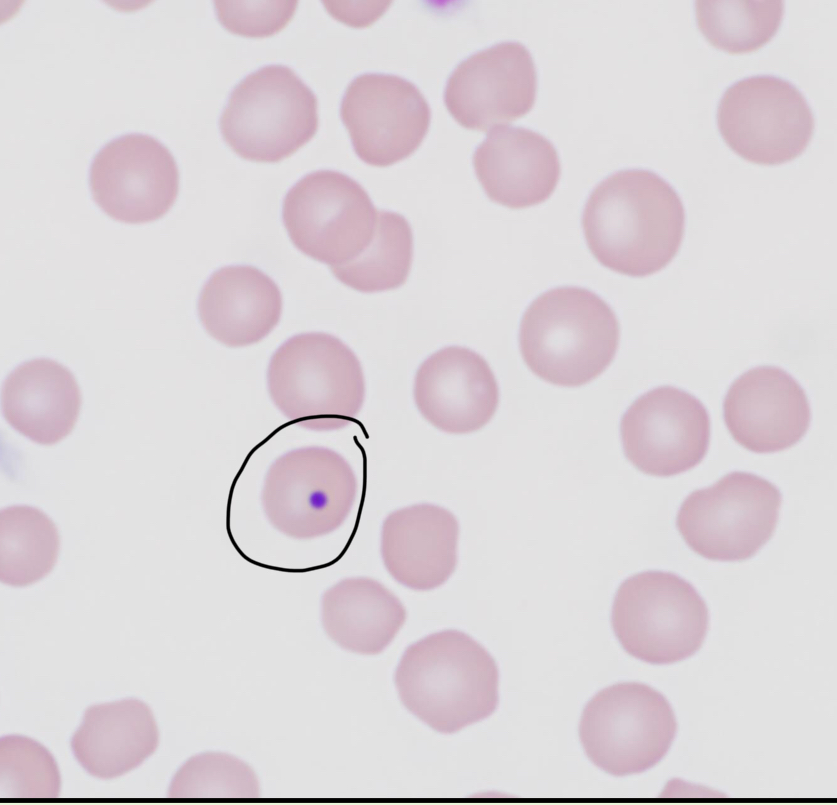
<p>What RBC inclusion is depicted in this image?</p>
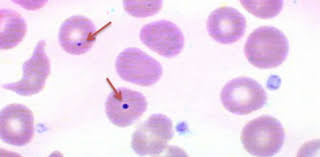
<ul><li><p>They are associated with regenerative anemias/splenectomy</p></li><li><p>Corticosteroid use</p></li><li><p>Chemotherapeutics</p></li></ul><p></p>
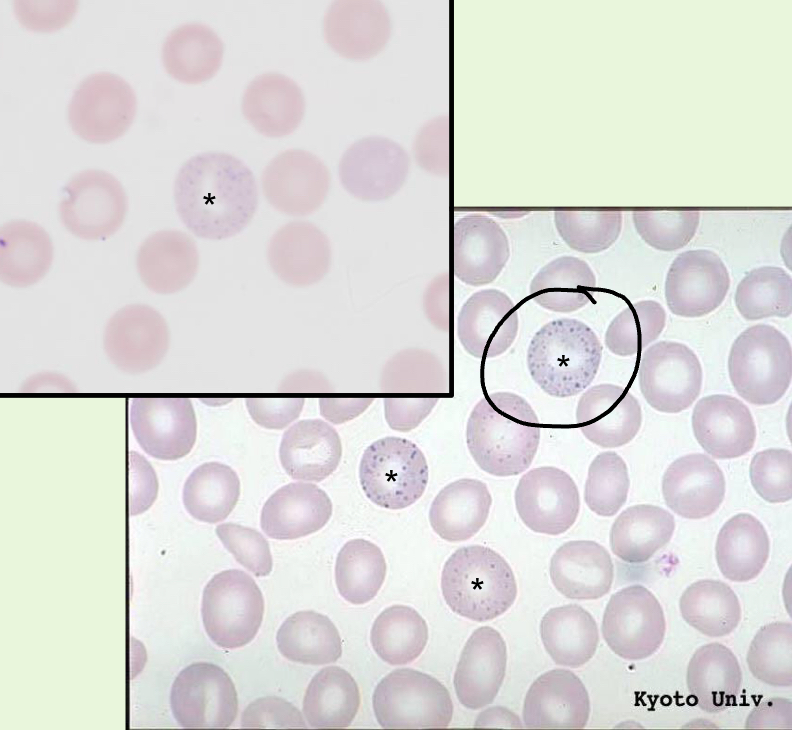
<p>What RBC inclusion is depicted in this image?</p>

Erythrocyte Morphology Changes, Inclusions, and infectious agents
1/42
There's no tags or description
Looks like no tags are added yet.
Name | Mastery | Learn | Test | Matching | Spaced | Call with Kai |
|---|
No study sessions yet.
43 Terms
Which species does not have mature nucleated RBCs?
Camelids

What does this picture deptict?
Rouleau/Rouleaux

What RBC morphology abnormality is depicted?
Agglutination
Agglutination cannot be differentiated from normal RBC “clumping“ until what is performed?
A saline dispersion test
If it is normal clumping (Rouleaux), then the RBCs should disperse, but if they remain together then it is agglutination
What is a Poikilocyte?
Any erythrocyte with an abnormal shape (general term)

Acanthocyte

Acanthocytes can appear similar to the RBCs in the image on the right, what is the name for these RBCs?
Crenated Cells
What is the clinical significance of Acanthocytes?
Hemangiosarcomas, osteosarcomas, lymphoma
Disorder of nearly any organ in the body
GI,musculoskeletal, renal, immune-mediated, etc.

Codocytes
What is the pathogenesis of codocytes?
Excessive membrane relative to HGB content
What is the clinical significance of finding Codocytes?
Regenerative anemias
Hepatic, renal, lipid disorders
Iron Deficiency
Jeuvos Rancheros= cheese (lipids), modelo (liver+renal),

What type of RBC morphological abnormalities could you see if an animal has iron deficiency?***
Codocytes (60)
Keratocyte
Ovalcyte/Eliptocyte
Schistocyte
Dacrocyte (tear-shaped)

Eccentrocyte
What is the clinical significance of finding Eccentrocytes?
Oxidative Damage

Echinocyte

Keratocyte
What is the clinical significance of finding Keratocytes?
Vasculitis, intravascular coagulation, endocarditis, hemangiosarcoma
Feline liver disease, doxorubicin (chemo-antibiotic) toxicosis in cats
Myelodysplastic disorders
Iron deficiency
What 2 morphological RBC abnormalities are hallmark indicators of oxidative damage?
Eccentrocytes
Heinz bodies

Ovalcytes/Eliptocytes
What is the clinical significance of finding Ovalcytes/Eliptocytes?
Myelofibrosis
Iron deficiency

Schistocyte
Schizo = cut
What is the clinical significance of finding Shistocyte?
Hemangiosarcoma
Intravascular coagulation
Vasculitis
Hepatic disease
Caval syndrome of dirofilaria, endocarditis, heart failure
Iron deficiency

Spherocyte
Lack central pallor (one solid color)
Smaller than RBCs (look similar to microcytes)
What is the clinical significance of finding Spherocytes?
IMHA (very common)
Fragmentation hemolysis
Envenomation
Zinc toxicosis
IMHA is at the top of your differential list when spherocytes are present

Stomacyte (Eye of sauron)
What is the clinical significance of finding Stomacytes?
Artifact of thick smears
Hereditary stomatocytosis
Amphipathic drugs
Young erythrocytes
What RBC inclusion is depicted in this image?
Howell-Jolly Bodies
What are Howell-Jolly Bodies?
Small spherical nuclear remnants (usually a dark purple circle in RBCs)
What is the clinical significance of finding Howell-Jolly Bodies?
They are associated with regenerative anemias/splenectomy
Corticosteroid use
Chemotherapeutics

What RBC inclusion is depicted in this image?
Heinz Bodies
What is the clinical significance of finding Heinz Bodies?
Overwhelming oxidative damage
Multitude of causes
Hyperthyroidism, Diabetes mellitus, lymphomas
What are Heinz bodies?
Large aggregate of oxidized/precipitated hemoglobin that are attached to the internal surfaces of erythrocytes

T/F: The presence of some heinz bodies can be normal in cats
True!
What RBC inclusion is depicted in this image?
Basophilic Stippling
This is dispersed ribosomes/polyribiosomes that have aggregated together
These can be confused wtih Reticulocytes/WBCs
Basophilic stippling occurs inside of RBCs, so they will be the same size as other RBCs

Siderotic inclusions
Howell-Jolly bodies
Course basophilic stippling
Fine basophillic stippling

Cabot Rings
What are the 2 main erythrocyte infectious agents of North America?
Hemotropic Mycoplasma
Cytauxzoon felis

What infectious organism of RBCs is this?
Hemotropic Mycoplasma
Gram -ve cocci
They attach to the external surfaces of erythrocytes (can fall off)
Bc they attach to the exterior, they can also form chains across RBCs
What is the clinical significance of finding Hemotropic Mycoplasma?
Can cause IMHA

Babesia spp.

Cytauxzoon felis
Cignet ring look, very similar to small babesia and can be hard to differentiate

Small Babesia spp.
Cytauxzoon felis
These can appear very similar, thus making pathologists rely on other methods of confirmation (PCR)